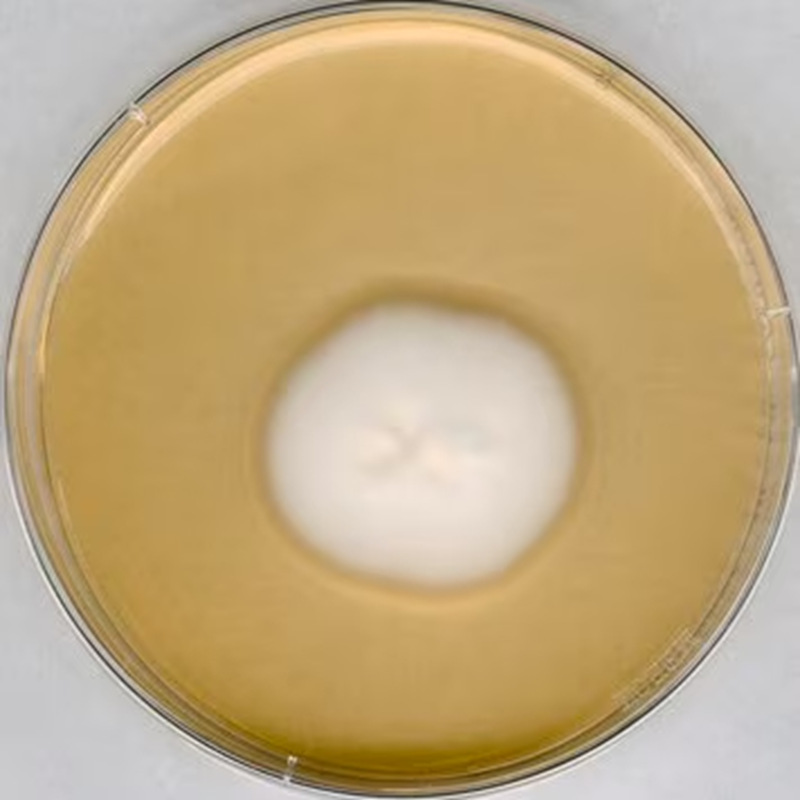
1.05438.0500 Merck 默克 GranuCult 沙氏4%葡萄糖琼脂

1688工业品为您提供在线免费查询更多化学试剂详细参数、实时报价、规格一览表。更多关于化学试剂多少钱一件/化学试剂报价明细/化学试剂规格型号价格表/化学试剂批发市场价格/化学试剂官方报价等咨询,尽在1688工业品。询底价>
为你找到其他化学试剂相关产品

叔丁醇钠 STB 医CP级 含量99% 第三丁氧基钠 865-48-5

湖北武汉
在线询价

(S)-(-)-2-氯丙酸 29617-66-1 样品 1kg 25kg 大小包装供应
湖北武汉
在线询价

Cy3 Acid(mono SO3) CAS:644979-14-6
河南郑州
在线询价

现货 醇溶 水彩笔用 邻甲酚酞 白色 酸碱指试剂 596-27-0
辽宁沈阳
在线询价

乙二胺四乙酸二钾 分析纯AR100g 西陇 EDTA二钾盐 CAS号2001-94-7
湖南长沙
在线询价

淀粉酶(AMS)检测试剂盒
上海
在线询价

魏氏试剂 6-溴异香草醛—2973-59-3 现货库存 质量保障
湖北武汉
在线询价
1.05438.0500 Merck 默克 GranuCult 沙氏4%葡萄糖琼脂
福建福州
在线询价

NBB-A培养基啤酒有害菌培养基NBB-B培养基用于啤酒中厌氧菌的检测
广东中山
在线询价

Muller固定液
上海
在线询价

工业氦气厂家 江 岸永清 10升碳钢包装 按需批发 万润达
湖北鄂州
在线询价

魏氏试剂 阿苯达唑亚砜—54029-12-8 现货库存 质量保障
湖北武汉
在线询价
查看更多产品及报价
100+其他化学试剂相关产品等你解锁
在线寻源3000行家正在找货
免费询价,源头正品,上1688工业品,全国的工业正品交易平台





